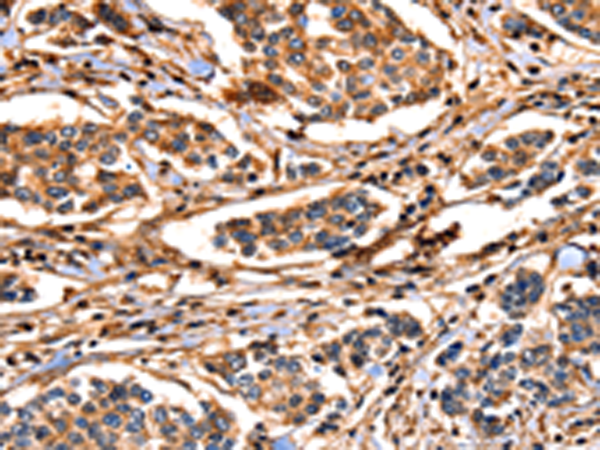

中文名稱:兔抗ANXA6多克隆抗體
|
Background: |
Annexin VI belongs to a family of calcium-dependent membrane and phospholipid binding proteins. Several members of the annexin family have been implicated in membrane-related events along exocytotic and endocytotic pathways. The annexin VI gene is approximately 60 kbp long and contains 26 exons. It encodes a protein of about 68 kDa that consists of eight 68-amino acid repeats separated by linking sequences of variable lengths. It is highly similar to human annexins I and II sequences, each of which contain four such repeats. Annexin VI has been implicated in mediating the endosome aggregation and vesicle fusion in secreting epithelia during exocytosis. Alternatively spliced transcript variants have been described. |
|
Applications: |
ELISA, WB, IHC |
|
Name of antibody: |
ANXA6 |
|
Immunogen: |
Fusion protein of human ANXA6 |
|
Full name: |
annexin A6 |
|
Synonyms: |
ANX6, CBP68 |
|
SwissProt: |
P08133 |
|
ELISA Recommended dilution: |
1000-2000 |
|
IHC positive control: |
Human breast cancer and human colon cancer |
|
IHC Recommend dilution: |
25-100 |
|
WB Predicted band size: |
76 kDa |
|
WB Positive control: |
293T cells |
|
WB Recommended dilution: |
200-500 |

購物車
幫助
021-54845833/15800441009
